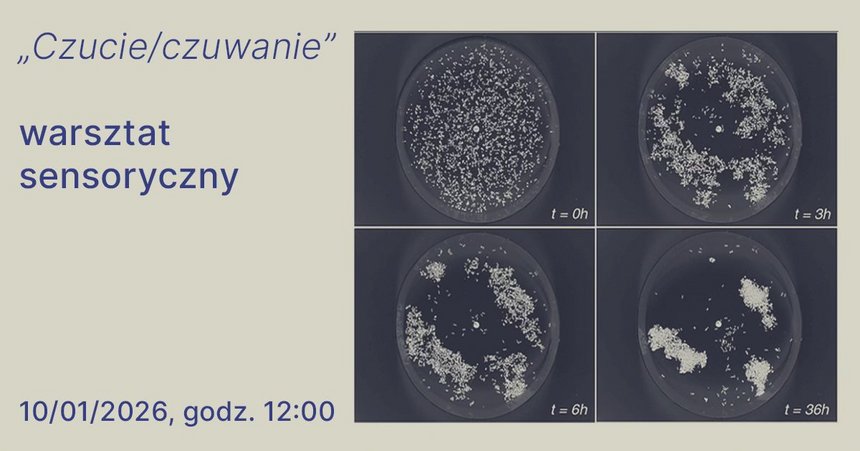

Czucie to zdolność odbierania i przetwarzania bodźców za pomocą zmysłów, obejmująca proste wrażenia (dotyk, temperatura, ból, równowaga) przekazywane przez receptory do mózgu, a także szersze aspekty, takie jak intuicja, przeczuwanie czy emocjonalne reagowanie na rzeczywistość, angażujące zarówno procesy fizjologiczne, jak i psychiczne.
Czuwanie – stan aktywności układu somatycznego, będący przeciwieństwem snu, który jest spoczynkiem dla tego układu. U ludzi dorosłych czuwanie i sen to dwa podstawowe stany fizjologiczne występujące cyklicznie, gdzie około 2/3 doby przypada na czuwanie.
Zapraszamy wszystkie nosy na sensoryczny warsztat towarzyszący wystawie „Perfumeryzm”, trwającej w Kamienicy Hilarego Majewskiego. Wystawie, która angażuje zmysł powonienia, opowiada o nim. To, co ważne w odbiorze prac powstałych w tym kierunku, to nosy. Nosy bezwzględnie muszą być obecne!
P.S. Osoby z wszelkimi doświadczeniami i uwarunkowaniami węchowymi mile widziane.
P.S. II. W trakcie warsztatu będziemy wąchać i smakować - pamiętaj, jeśli masz alergię, poinformuj nas o tym przy zgłoszeniu.
Wstęp wolny
Obowiązują zapisy: 534 180 876 lub na adres mailowy edukacja@inlodz21.pl